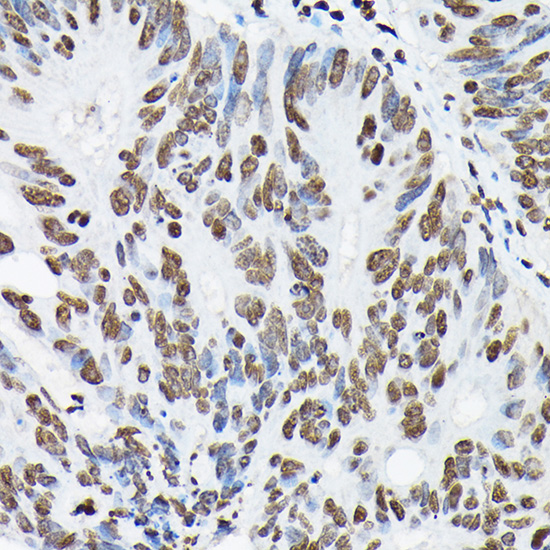

Product Name :
DiMethyl-Histone H3-K9 polyclonal antibody Background :
Histones are basic nuclear proteins that are responsible for the nucleosome structure of the chromosomal fiber in eukaryotes. Nucleosomes consist of approximately 146 bp of DNA wrapped around a histone octamer composed of pairs of each of the four core histones (H2A, H2B, H3, and H4). The chromatin fiber is further compacted through the interaction of a linker histone, H1, with the DNA between the nucleosomes to form higher order chromatin structures. This gene is intronless and encodes a replication-dependent histone that is a member of the histone H3 family. Transcripts from this gene lack polyA tails; instead, they contain a palindromic termination element. This gene is located separately from the other H3 genes that are in the histone gene cluster on chromosome 6p22-p21.3. Product :
1mg/ml in PBS with 0.02% sodium azide, 50% glycerol, pH7.2 Storage&Stability :
Store at 4°C short term. Aliquot and store at -20°C long term. Avoid freeze-thaw cycles. Specificity :
Methylated Antibodies Immunogen :
A synthetic dimethylated peptide around K9 of human histone H3(NP_003520.1). Conjugate :
Unconjugated Modification :
Methylated
DiMethyl-Histone H3-K9 polyclonal antibody Background :
Histones are basic nuclear proteins that are responsible for the nucleosome structure of the chromosomal fiber in eukaryotes. Nucleosomes consist of approximately 146 bp of DNA wrapped around a histone octamer composed of pairs of each of the four core histones (H2A, H2B, H3, and H4). The chromatin fiber is further compacted through the interaction of a linker histone, H1, with the DNA between the nucleosomes to form higher order chromatin structures. This gene is intronless and encodes a replication-dependent histone that is a member of the histone H3 family. Transcripts from this gene lack polyA tails; instead, they contain a palindromic termination element. This gene is located separately from the other H3 genes that are in the histone gene cluster on chromosome 6p22-p21.3. Product :
1mg/ml in PBS with 0.02% sodium azide, 50% glycerol, pH7.2 Storage&Stability :
Store at 4°C short term. Aliquot and store at -20°C long term. Avoid freeze-thaw cycles. Specificity :
Methylated Antibodies Immunogen :
A synthetic dimethylated peptide around K9 of human histone H3(NP_003520.1). Conjugate :
Unconjugated Modification :
Methylated
-
 Western blot analysis of extracts of various cell lines, using DiMethyl-Histone H3-K9 antibody at 1:1000 dilution.
Western blot analysis of extracts of various cell lines, using DiMethyl-Histone H3-K9 antibody at 1:1000 dilution.
Secondary antibody: HRP Goat Anti-Rabbit IgG at 1:10000 dilution.
Lysates/proteins: 25ug per lane.
Blocking buffer: 3% nonfat dry milk in TBST.
Detection: ECL Basic Kit .
Exposure time: 180s. -
 Dot-blot analysis of all sorts of methylation peptides using DiMethyl-Histone H3-K9 antibody .
Dot-blot analysis of all sorts of methylation peptides using DiMethyl-Histone H3-K9 antibody . -
 Dot-blot analysis of all sorts of methylation peptides using DiMethyl-Histone H3-K9 antibody .
Dot-blot analysis of all sorts of methylation peptides using DiMethyl-Histone H3-K9 antibody . -
Dot-blot analysis of all sorts of methylation peptides using DiMethyl-Histone H3-K9 antibody .
Dot-blot analysis of all sorts of methylation peptides using DiMethyl-Histone H3-K9 antibody .
CD49f promotes proliferation of male dairy goat germline stem cells
PMCID: Pubmed No.:26841372
CD49f promotes proliferation of male dairy goat germline stem cells
PMCID: Pubmed No.:26841372
Fenoxaprop-ethyl affects mouse oocyte quality and the underlying mechanisms
PMCID: Pubmed No.:30152098
Multiple superovulations alter histone modifications in mouse early embryos
PMCID: Pubmed No.:30884466
Bioworld Biotech only provide peptides for our antibodies and do not provide additional peptide customization services.
Price/Size :
USD 368/1mg/vial
Tips:
For phospho antibody, we provide phospho peptide(0.5mg) and non-phospho peptide(0.5mg).Describe :
Blocking peptides are peptides that bind specifically to the target antibody and block antibody binding. These peptide usually contains the epitope recognized by the antibody. Antibodies bound to the blocking peptide no longer bind to the epitope on the target protein. This mechanism is useful when non-specific binding is an issue, for example, in Western blotting (WB) and Immunohistochemistry (IHC). By comparing the staining from the blocked antibody versus the antibody alone, one can see which staining is specific; Specific binding will be absent from the western blot or IHC performed with the neutralized antibody.Formula:
Synthetic peptide was lyophilized with 100% acetonitrile and is supplied as a powder. Reconstitute with 0.1 ml DI water for a final concentration of 10 mg/ml.The purity is >90%,tested by HPLC and MS.
Storage:
The freeze-dried powder is more stable. For short time at 2-8°C. For long term storage store at -20°C.
Note :
This product is for research use only (RUO only). Not for use in diagnostic or therapeutic procedures.
 DiMethyl-Histone H3-K9 polyclonal antibody
DiMethyl-Histone H3-K9 polyclonal antibody  Datasheet
Datasheet COA
COA MSDS
MSDS SHIP
SHIP